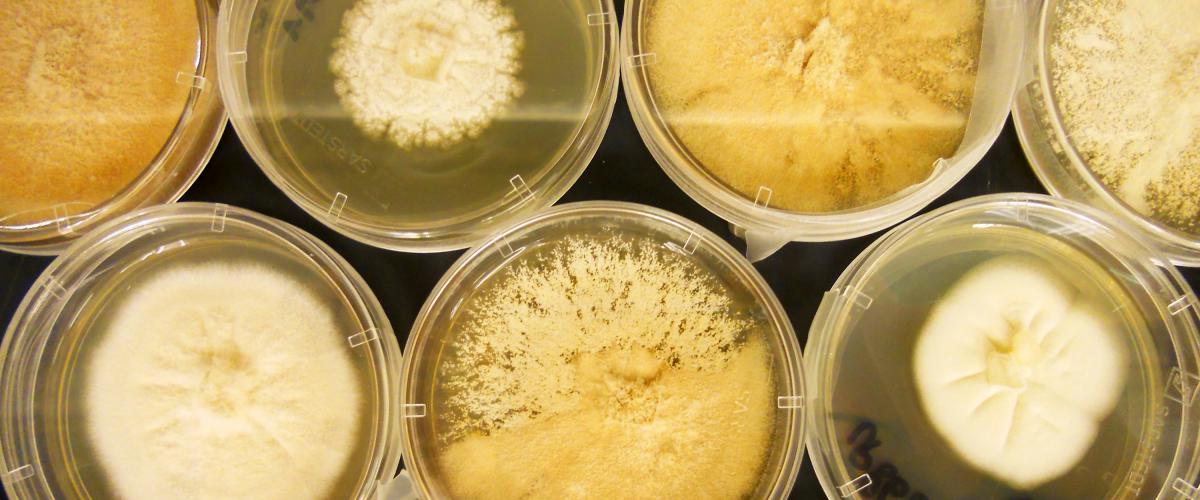

Bij schimmels denk je niet zo gauw aan de zee, maar ze komen er wel in voor. In het zeewater zitten veel kleine, meestal ééncellige schimmels, die bijna allemaal tot de phycomyceten behoren. Sommige veroorzaken ziekten en kunnen bijvoorbeeld vissen, kreeftachtigen en wieren aantasten. Andere zeeschimmels zweven vrij in het water, of hechten zich aan drijfhout, schelpen en zandkorrels op de zeebodem. De schimmels die vrij in het water zweven hebben uitsteeksels om beter te kunnen blijven drijven. Schimmels zijn gespecialiseerd in de afbraak van stoffen en kunnen bijvoorbeeld hout of lege pantsers van kreeftachtigen afbreken.
Voortplanting
De voortplanting vindt plaats door middel van sporen. Die kunnen lang op de bodem blijven liggen tot ze iets vinden waardoor ze kunnen groeien. Vaak hebben ze een zweepstaartje (net als een sperma-cel), waardoor ze een beetje kunnen zwemmen.
1200px-Morelasci.jpg

Verspreiding van de zeeschimmels
Je vindt de zeeschimmels vooral in de buurt van de kust, tot 2000 sporen per liter. Daar is voedsel in de vorm van kleine stukjes dode planten en dieren die in het water zweven en van het land komen. Veel schimmels kunnen zich in zee ook niet voortplanten. Daarvoor hebben ze zoet water nodig. Verderop in de Noordzee vind je maar 10 sporen per liter.
In de zuurstofloze zwarte plekken op het wad komen naast bijzondere bacteriën ook ééncellige gisten voor. Die vergisten daar de suikers uit organische stoffen, net zo als hun soortgenoten bij bakkerijen en bierbrouwerijen doen.
Schimmels zijn afbraakspecialisten
In de tijd dat netten en touwen nog van natuurlijke materialen gemaakt werden konden bepaalde schimmels, de zeevaart en de visserij binnen enkele weken of maanden aanzienlijke schade toebrengen. De touwen en de netten verschimmelden als ze niet goed gedroogd konden worden. Het weer zit er in, zei men dan. Ook houten scheepswrakken zijn niet veilig voor de schimmels. Met de huidige netten van nylon en andere soorten plastic kunnen schimmels zich niet voeden. Rondzwervende netten worden tegenwoordig dus ook niet meer afgebroken, met alle gevolgen voor de zeefauna van dien.
Zeeschimmels als ziekteverwekkers
Sommige zeeschimmels, bijvoorbeeld Ichthyophonus hoferi, kunnen visziekten veroorzaken. Terwijl haring en schol een besmetting met deze schimmel niet overleven, kunnen kabeljauwachtigen meestal wel herstellen. Zowel de ingewanden als het huidweefsel van de vis worden aangetast. Gelukkig kan deze schimmel niet leven in zoogdieren.
Andere schimmels vestigen zich op kalk en kunnen bijvoorbeeld de tanden van zeewolven aantasten. De schimmel kan de kalk oplossen.
De schimmel Labyrinthula tast zeegras aan en kan daarbij een massale sterfte veroorzaken. Kleurloze vlekken op groenwieren kunnen door deze schimmel veroorzaakt zijn. Ook kiezelwieren kunnen door deze schimmels aangetast raken.
Toekomstmuziek
Zeeschimmels zijn nog maar weinig onderzocht, er is dus nog niet zo veel over geweten. Onderzoekers denken dat zeeschimmels mogelijks heel wat stoffen aanmaken die nuttig kunnen zijn voor de mens. Er wordt gekeken naar de rol die zeeschimmels kunnen spelen in het verwerken van afval. Sommige stoffen van zeeschimmels doden bacteriën en zouden dus kunnen werken als antibioticum. Recent is ook ontdekt dat de zeeschimmel Scopulariopsis brevicaulis stoffen maakt die de groei van bepaalde kankercellen kunnen tegengaan. Het is dus zeker de moeite om deze schimmels verder te onderzoeken!
5694914076_0295def42c_b.jpg
